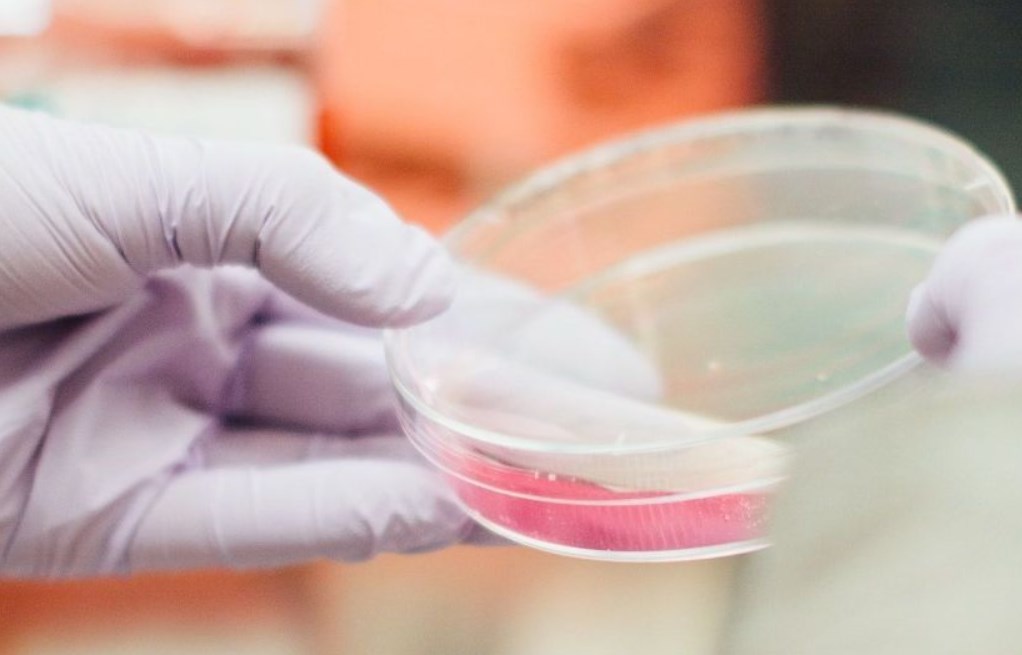
1agepats

А гепатит у Чернігові не здається
У Чернігові зафіксовано два випадки захворювання на гепатит типу А у дошкільнят, які дома, на побутовому рівні, контактують з учнями та працівниками школи №7.
Про це повідомила начальник Чернігівського міського управління ГУ Держспоживслужби в області Валентина Михед: "У дитсадку №69 на гепатит захворіла дівчинка, в якої родичка працює в харчоблоку 7-ї школи. А трохи раніше хворобу виявили у хлопчика з дитсадка №45. Він, імовірно, заразився від старшого брата - учня цієї ж школи. Тобто, маємо наслідки побутових контактів, пов'язаних зі спалахом у 7-й школі, і з цим нічого не поробиш. Однак, у дитсадках проблема вирішується простіше: групи там мають окремі входи, окремі майданчики і контакт дітей - мінімальний".
Про це повідомила начальник Чернігівського міського управління ГУ Держспоживслужби в області Валентина Михед: "У дитсадку №69 на гепатит захворіла дівчинка, в якої родичка працює в харчоблоку 7-ї школи. А трохи раніше хворобу виявили у хлопчика з дитсадка №45. Він, імовірно, заразився від старшого брата - учня цієї ж школи. Тобто, маємо наслідки побутових контактів, пов'язаних зі спалахом у 7-й школі, і з цим нічого не поробиш. Однак, у дитсадках проблема вирішується простіше: групи там мають окремі входи, окремі майданчики і контакт дітей - мінімальний".
За словами Михед, дітей госпіталізували, а в дитсадках фахівці обласного лабораторного центру МОЗ України провели дезінфекцію. Батькам рекомендували, по-можливості, залишати малюків удома.
Як повідомлялося, спалах гепатиту типу А в чернігівській ЗОШ №7 розпочався у третій декаді жовтня. З 21 по 27 число було госпіталізовано перших 16 учнів. А раніше з таким діагнозом у лікарню потрапила працівниця харчоблоку школи. Станом на 10 грудня в школі зареєстровано 41 хворого (30 дітей та 11 дорослих), зі стаціонару виписано 31 особу.
За інформацією Укрінформу






